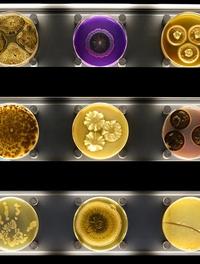

FOMO : un bovarysme 2.0 ?

Paris, le samedi 31 janvier 2015 - Sur les réseaux sociaux s’alimentent les contes et légendes de nos existences. Il s’agit de livrer, le plus régulièrement possible, à ses « amis » une version améliorée de sa petite vie. Cette dernière est donc dorénavant jalonnée par la mise en ligne de photographies [...]